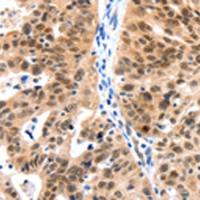
兔抗LRP5多克隆抗体

万千商家帮你免费找货
0 人在求购买到急需产品
- 详细信息
- 技术资料
- 抗体名:
CDC23抗原(重组蛋白)
- 抗体英文名:
CDC23 Antigen (Recombinant Protein)
- 应用范围:
仅供科研实验研究
- 供应商:
上海酶联生物科技有限公司
- 库存:
69
- 保质期:
1年
- 适应物种:
动物
- 保存条件:
冷冻(-20℃)
- 形态:
液体
- 规格:
100ug/1mg
| 规格: | 100ug | 产品价格: | ¥800.0 |
|---|---|---|---|
| 规格: | 1mg | 产品价格: | ¥3580.0 |
中文名称 : CDC23抗原(重组蛋白)
英文名称 : CDC23 Antigen (Recombinant Protein)
别 名:cell division cycle 23; APC8; CUT23; ANAPC8
相关类别 : 抗原
储 存:冷冻(-20℃)
概述
Fusion protein corresponding to a region derived from 398-597 amino acids of human CDC23
产品的优势:
♦ 雄厚的技术力量,科研专家进行技术研发。
♦ 高品质大品牌的抗体,保证检测的灵敏度和特异性。
♦ 先进的实验优化方案----重复性高,可靠性强。
♦ 全天候的技术支持,专业、高效、耐心。
♦ 可检测指标齐全。
♦ 专家级规范操作,结果更准确,时间更迅速。
CDC23抗原(重组蛋白)力争为科研用户提供为专业化的服务与产品,全力帮助客户在各自领域不断取得新的突破和更大的成绩;我公司长期跟各大高校科研实验室保持课题合作,经验丰富,质量稳定,我们所有的产品都是我司直接供货,无中间差价,直接供货,让您以实惠的实验预算完成您的实验。
酶联合作流程:
产品报价:一对一服务及时响应
签订合同:确定下单,正式合同
售后服务:全程技术支持,质量问题包退换
物流配送:现货库存,24h发货
同规格抗体产品:
风险提示:丁香通仅作为第三方平台,为商家信息发布提供平台空间。用户咨询产品时请注意保护个人信息及财产安全,合理判断,谨慎选购商品,商家和用户对交易行为负责。对于医疗器械类产品,请先查证核实企业经营资质和医疗器械产品注册证情况。
技术资料CDC23抗原(重组蛋白)
¥800 - 3580